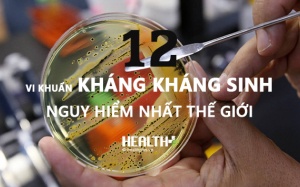
Vì sao WHO phải công bố gấp danh sách 12 siêu vi khuẩn nguy hiểm nhất?

25/09/2018 14:30
Nghiên cứu cho thấy, nếu bạn không bị nhiễm trùng, thuốc kháng sinh có thể gây hại cho sức khỏe của bạn, khiến bạn dễ bị nhiễm bệnh hơn.
07/09/2018 17:02
Các nhà khoa học Australia cảnh báo một loại siêu vi trùng kháng mọi loại thuốc kháng sinh rất khó phát hiện, có thể gây ra nhiễm trùng nặng hoặc thậm chí gây tử vong và đang lan rộng tại...
01/09/2018 15:00
Trẻ sơ sinh uống thuốc kháng sinh là điều chẳng ai mong muốn, nhưng nếu mắc bệnh do nhiễm khuẩn thì buộc phải dùng. Dùng thuốc kháng sinh cho trẻ nhỏ nên làm gì để không hại sức khỏe?
03/05/2018 11:13
Chào bác sỹ! Con trai tôi năm nay 4 tuổi và bé thường xuyên bị mắc các bệnh nhiễm trùng. Mỗi lần đi khám, bé đều được chỉ định dùng kháng sinh. Thường xuyên mắc bệnh có phải là...
07/02/2018 08:54
Chiều ngày 5/2, Bệnh viện Bệnh nhiệt đới Trung ương (cơ sở Kim Chung, Đông Anh, Hà Nội) đã chính thức cắt băng khánh thành Phòng xét nghiệm tham chiếu về kháng kháng sinh với tổng vốn...
30/11/2017 06:30
Tổ chức Y tế thế giới (WHO) thống kê, tại các nước đang phát triển, cứ 10 viên thuốc thì lại có 1 viên là giả hoặc kém chất lượng. Điều này có thể gây tử vong cho hàng chục ngàn trẻ...
- Chỉ dẫn giúp phục hồi cơ thể sau khi uống thuốc kháng sinh
- Cảnh báo: Kháng sinh thế hệ 1&2 đã không còn tác dụng đặc hiệu
- WHO cảnh báo: Thế giới đang dần cạn kiệt thuốc kháng sinh
- VAFF và VATAP ký kết phối hợp hành động chống hàng giả, TPCN kém chất lượng
- VAFF phối hợp với VATAP chống hàng giả, hàng nhái, TPCN kém chất lượng
29/03/2017 16:37
Cô con gái mới biết đi của tôi bị nhiễm trùng tai liên tục. Cháu thường xuyên phải uống kháng sinh. Liệu rằng dùng kháng sinh nhiều như vậy có ảnh hưởng xấu đến sức khỏe của bé hay...
25/03/2017 12:03
Nhiễm trùng đường tiểu có thể khiến bạn bị đi tiểu thường xuyên, đau vùng chậu... Tuy nhiên nếu bạn đang mắc 5 sai lầm dưới đây thì tình trạng nhiễm trùng đường tiểu của bạn...
01/03/2017 11:40
Lần đầu tiên, Tổ chức Y tế thế giới (WHO) công bố một danh sách các loại vi khuẩn siêu kháng thuốc (vi khuẩn kháng kháng sinh) nguy hiểm hàng đầu thế giới.
06/02/2017 12:57
Một loại kháng sinh có khả năng tiêu diệt vi khuẩn bằng cách phá tan nó với siêu sức mạnh, một phương pháp chưa từng biết đến trước nay, có thể sẽ là nền tảng để tạo ra thế hệ...